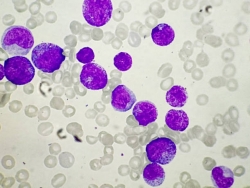

제1회 대한재택의료학회 추계 심포지엄, 고령사회 재택의료 활성화 방안 제안
고령화시대 재택의료 활성화를 위해 모호한 정의를 명확히하고 분절된 사업이 유기적으로 연계될 수 있도록 이를 통합·관리할 컨트롤타워가 필요하다는 전문가들 조언이 나왔다.대한재택의료학회는 최근 고려대학교 의과대학 본관 유광사홀에서 '제1회 추계 심포지엄'을 개최했다.'고령사회 재택의료 활성화를 위한 현황과 도전'을 주제로 열린 이번 심포지엄에서는 대학병원, 요양병원, 지역사회를 중심으로 재택의료를 펼치고 있는 현장 전문가들이 연사로 나서 생생한 경험을 소개하고 개선 과제를 공유했다.이건세 대한재택의료학회 회장은 "재…
2023-11-08 06:15:00